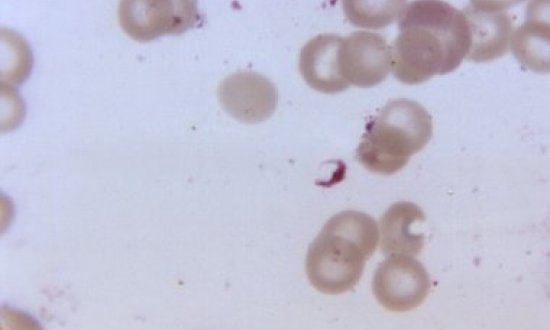

IDDO's governance structure includes an advisory Board appointed to oversee the strategic direction and execution of IDDO’s objectives. In addition, a Scientific Advisory Group has been appointed for each research theme to guide and feedback on programmatic activities. Please see the individual research themes for details of governance activities.
IDDO has a robust data governance framework to protect the privacy, integrity and security of data across the IDDO platform, with access to data overseen by IDDO’s independent Data Access Committees. These systems and procedures are detailed within the individual research themes.
The WorldWide Antimalarial Resistance Network (WWARN) is a collaborative platform generating innovative resources and reliable evidence to inform the malaria community on the factors affecting the efficacy of antimalarial medicines. WWARN is part of the Infectious Diseases Data Observatory (IDDO).